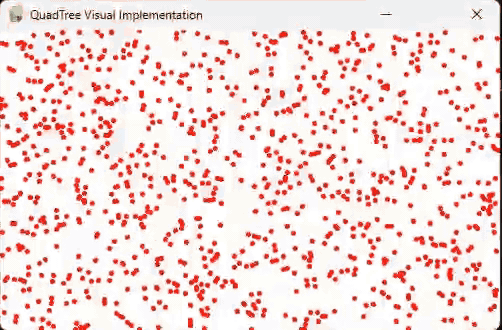
Quadtree Division System

Featured Programming Projects

Barnes-Hut Simulation
A gravitational N-body simulation using the Barnes-Hut algorithm and quadtrees for efficient clustering.

Laser Simulation
2D reflection-based ray simulation with dynamic surfaces and angle tracking using real-time rendering.
Quadtree Division System
Visual debugging tool for spatial partitioning and hierarchical sector subdivision in physics simulations.